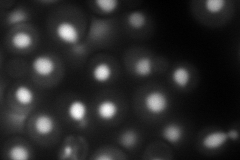
YPR086W
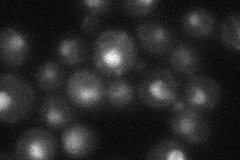
YPR086W
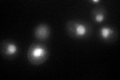
YPR086W

View description
Transcription factor TFIIB, a general transcription factor required for transcription initiation and start site selection by RNA polymerase II
Localization:
Intensity:
Fold change:
Significance:
-
C’ GFP library in SD

nucleus44.65 -
N' NOP1pr-GFP in SD

nucleus121.701 -
N' TEF2pr-mCherry in SD
nucleus181.283 -
N' NATIVEpr-GFP in SD
nucleus28.8008 -
N' TEF2pr-VC and Cyto-VN in SD

#N/A0 -
C’ GFP library in SD+DTT
nucleus42.80.95No -
C’ GFP library in SD+H2O2

nucleus41.140.92No -
C’ GFP library in Starvation Media

nucleus32.310.72No -
C’ GFP library on the background of Pup2-DaMP

nucleus -
C’ GFP library on the background of CCT mutant

nucleus45.58881.02094No
